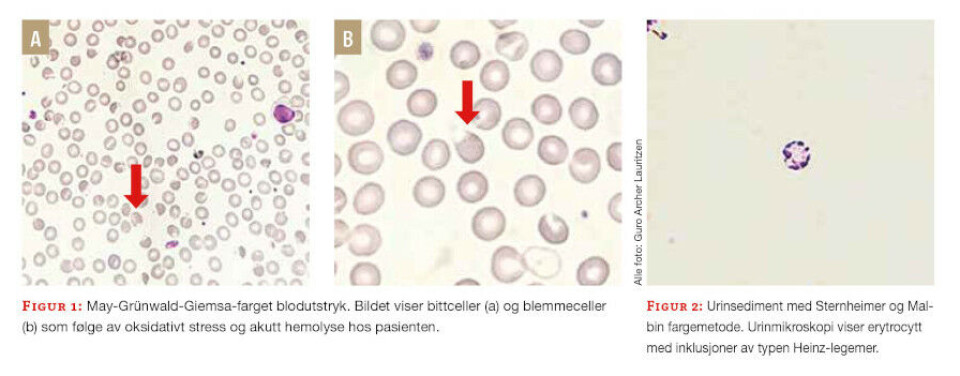

FAG resymé
En kasuistikk som illustrerer nytteverdien av bioingeniører som diagnostiske samarbeidspartnere
Blodutstryk og urinmikroskopi er hjørnesteiner i utredningen av hemolyse.
Av GURO ARCHER LAURITZEN, ERIK ØGLÆND BJØRNESTAD og LUDVIG NILS WIND DAAE
Vi publiserte nylig en kasuistikk i Tidsskrift for Den norske legeforening som belyser dette. Den illustrerer også viktigheten av en grundig anamnese og samarbeid mellom bioingeniører og klinikere.
Vi ønsker å rette søkelys på nytteverdien av morfologikunnskap og samarbeid på tvers av profesjoner, særlig mellom bioingeniører og klinikere. Kasuistikken beskriver blant annet hvordan en bioingeniør kan benytte og synliggjøre sin kompetanse.
Mann med magesmerter og ikterus
En mann i 20-årene fra Midtøsten ble innlagt på sykehus grunnet magesmerter. Han ble henvist fra legevakt til akuttmottaket med mistanke om gallestein. Det var vakthavende bioingeniør som tok blodprøver av den aktuelle pasienten ved innkomst. Hun var opplært i hematologisk diagnostikk, inkludert blodutstryk og urinmikroskopi. I tillegg var bioingeniøren vant med å arbeide som diagnostisk samarbeidspartner i akuttmottaket. Derfor var det naturlig å diskutere pasienten med vakthavende lege.
Bioingeniøren mistenkte hemolyse
Bioingeniøren analyserte blodprøvene, og kombinasjonen av anemi, hyperbilirubinemi og melding fra hematologiinstrumentet om kjerneholdige erytrocytter, førte til mistanke om hemolyse. Bioingeniøren konfererte med klinikere og informerte om mistanken. Hun etterbestilte blant annet haptoglobin og retikulocytter, som viste utslettet haptoglobin og lett retikulocytose.
Bioingeniøren vurderte blodutstryk fra prøven umiddelbart og de viktigste funnene var aniso- og poikilocytose med bittceller (bite cells) og blemmeceller (blister cells) (figur 1A og B), samt en del kjerneholdige erytrocytter.
Vår pasient hadde normocytær anemi, som sammen med lett retikulocytose, hyperbilirubinemi og bortfall av haptoglobin styrket mistanken om pågående hemolyse.
Blodutstryk og urinmikroskop
Blodutstryk er et nyttig diagnostisk verktøy, som kan gi hurtige og presise avklaringer ved blant annet hemolyse. Anisocytose betyr at det er størrelsesvariasjon blant erytrocyttene. Poikilocytose betyr formvariasjon blant erytrocyttene. Bittceller er erytrocytter som mangler en «bit». Dette «bittet» er en konsekvens av at makrofagene i milten forsøker å bryte ned oksidativt skadde erytrocytter. Funn av kjerneholdige erytrocytter er ofte et tegn på akselerert erytropoiese.
På bakgrunn av funn i blodutstryk anbefalte bioingeniøren urinprøve til strimmeltest og mikroskopi. Rødbrun urin gir mistanke om hemoglobinuri, og hemoglobinnedbrytningsprodukter i urin (utslag på blod ved strimmeltest) indikerer intravaskulær hemolyse. Det mest påfallende ved urinmikroskopien var funn av Heinz-legemer (figur 2). Dette er utfellinger av denaturert hemoglobin (1–3). Heinz-legemer i urin, samt funn av bittceller og blemmeceller i perifert blodutstryk, indikerte at pasientens hemolyse var forårsaket av oksidativ skade i erytrocyttene. Utredningen avdekket en tilstand som man sjelden ser i norske sykehus.
Favisme
Pasienten hadde i forkant av den aktuelle innleggelsen inntatt et måltid bestående av favabønner. Pasientens etnisitet, sammen med morfologi og anamnestiske opplysninger om en tidligere gjennomgått liknende hendelse, førte til at man fikk sterk mistanke om glukose-6-fosfatdehydrogenasemangel.
Enzymaktiviteten var < 10 %, forenlig med en alvorlig enzymmangel. Glukose-6-fosfatdehydrogenasemangel er den mest utbredte genetiske enzymdefekten på verdensbasis. Anslagsvis er det 400–500 millioner mennesker som har denne tilstanden, som er mest utbredt i middelhavslandene, Afrika, Asia og Midtøsten (1, 4).
Glukose-6-fosfatdehydrogenase er et nødvendig enzym for å beskytte erytrocyttene mot oksidativt stress (4). Pasientene er vanligvis symptomfrie frem til de eksponeres for en oksidativ «trigger», som kan være et legemiddel eller en interkurrent sykdom (4). En annen klassisk trigger er inntak av favabønner (bondebønner). Utvikling av hemolyse etter inntak av disse kalles favisme (1).
Diagnostisk samarbeidspartner
Blodutstryk med funn av bittceller og blemmeceller kan føre til raskere diagnostisering. Måling av aktivitet av glukose-6-fosfatdehydrogenase i erytrocytter vil gi en sikker diagnose. Dette er et av flere eksempler hvor bioingeniørene kan synliggjøre sin kompetanse som diagnostisk samarbeidspartner. Bioingeniører kan være de første som oppdager patologi. Da er det viktig at de informerer klinikere. Det kan bidra til raskere utredning og er til det beste for pasienten.